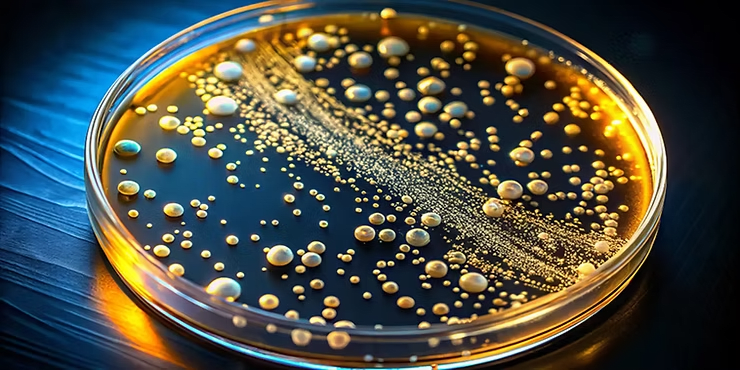
Metagenomic Profiling Method

NVIDIA Advances Robot Learning and Humanoid Development With New AI and Simulation Tools
Robotics developers can greatly accelerate their work on AI-enabled robots, including humanoids, using new AI and simulation tools and workflows

Robotics developers can greatly accelerate their work on AI-enabled robots, including humanoids, using new AI and simulation tools and workflows
Researchers at the Carnegie Mellon School of Computer Science and the University of Toronto have developed a new k-mer sketching

While there has been tremendous growth in scientific knowledge over the past 100 years, innovative activity appears to be slowing.

New research conducted by Carnegie Mellon University’s Heinz College of Information Systems and Public Policy and the Grantham Research Institute

On Oct. 24, NASA reconnected with the Voyager 1 spacecraft after a brief pause in communications. The spacecraft recently turned

Antonia’s kits at three-weeks old. Credit: Smithsonian’s NZCBI. The U.S. Fish and Wildlife Service and conservation partners are excited to

Lorem ipsum dolor sit amet, consectetur adipiscing elit. Ut elit tellus, luctus nec ullamcorper mattis, pulvinar dapibus leo. Tayia Oddonetto

An impressive operation recently took place in CERN’s magnet test hall. The innovative cold powering system has been successfully installed

At the Large Hadron Collider (LHC), heavy ions are accelerated to extremely high energies, which creates strong electromagnetic fields. As

China’s Einstein Probe (EP) astronomical satellite, sent into space in January this year, has achieved several initial discoveries, including a
We uphold the highest standards of journalistic integrity and ethical reporting, ensuring that truth and transparency prevail in all our content.
contact@modernmechanics.com